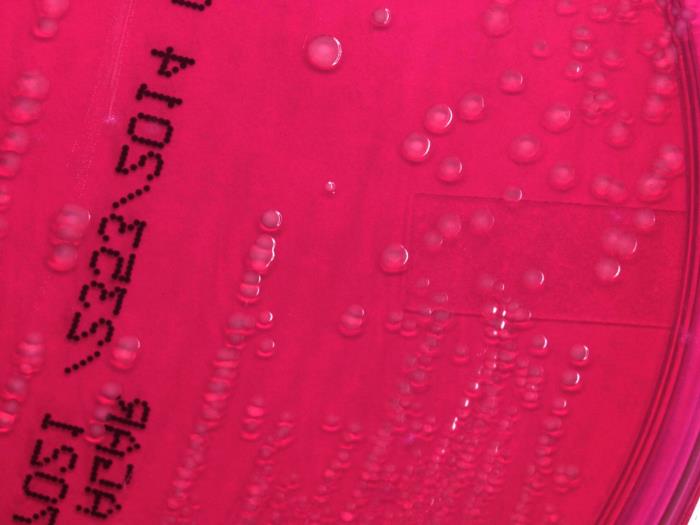

ملف:CDC 17192 Shigella sonnei XLD.jpg
CDC_17192_Shigella_sonnei_XLD.jpg (700 × 525 بكسل حجم الملف: 30 كيلوبايت، نوع MIME: image/jpeg)
وصف قصير
| Description |
English: Under the low-power, 10X magnification of a digital Keyence scope, this photograph depicts the colonial growth displayed by Gram-negative, Shigella sonnei bacteria, which were cultured on xylose-lysine-deoxycholate (XLD) agar medium, for a 72-hour time period, at a temperature of 37°C. |
| Date | 2014 |
| Source | قالب:CDC-PHIL |
| Author | Todd Parker, Ph.D., Assoc Director for Laboratory Science, Div of Preparedness and Emerging Infections at CDC |
| ⧼wm-license-information-permission⧽ (⧼wm-license-information-permission-reusing-text⧽) |
قالب:PD-USGov-HHS-CDC |
تاريخ الملف
اضغط على زمن/تاريخ لرؤية الملف كما بدا في هذا الزمن.
| زمن/تاريخ | صورة مصغرة | الأبعاد | مستخدم | تعليق | |
|---|---|---|---|---|---|
| حالي | ★ مراجعة معتمدة 14:56، 9 نوفمبر 2023 | 700 × 525 (30 كيلوبايت) | Pastakhov (نقاش | مساهمات) | Upload https://upload.wikimedia.org/wikipedia/commons/0/0c/CDC_17192_Shigella_sonnei_XLD.jpg |
لا يمكنك استبدال هذا الملف.
وصلات
لا يوجد صفحات تصل لهذه الصورة.